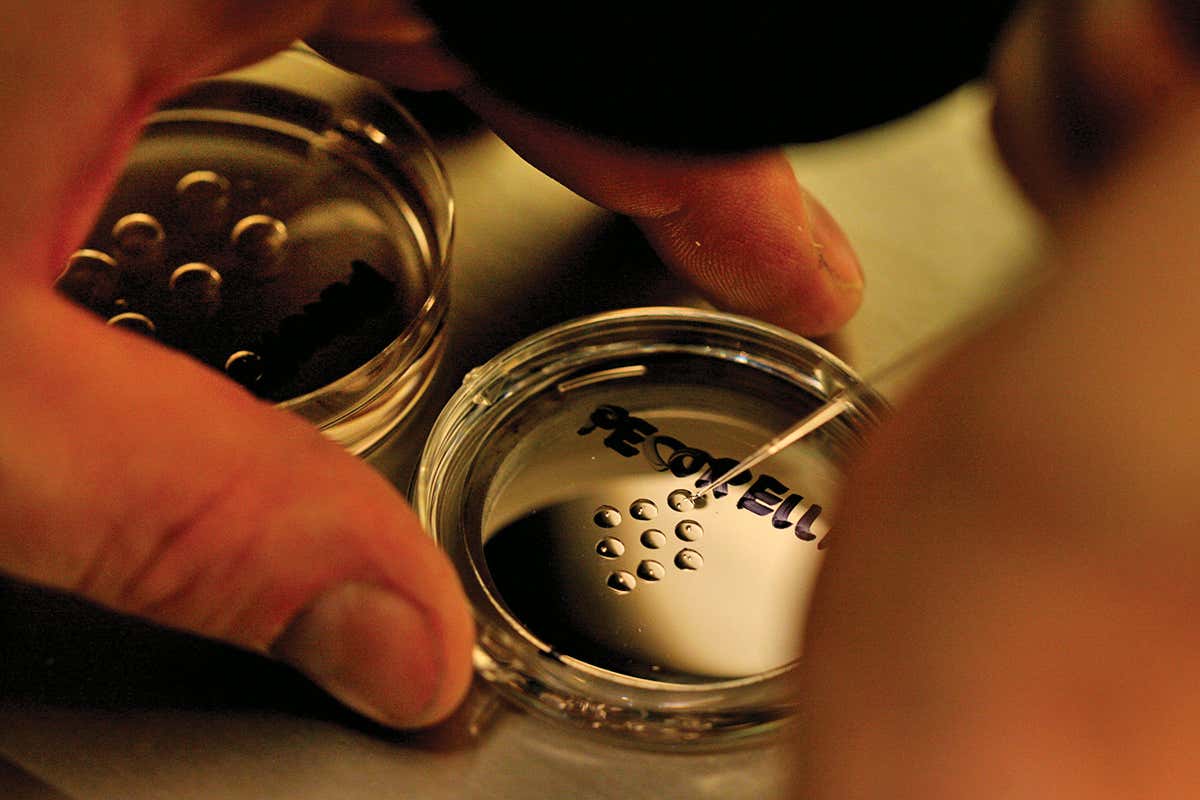
Researcher works on human embryos in dish

Scientific progress means old dilemmas will be revisited Sandy Huffaker/Corbis via Getty
How long should we let human embryos grow in the lab? Until now that question was largely academic. Going beyond 7 days in vitro was very rare, with 9 days the longest achieved.
Now two new milestone studies have managed to keep embryos growing for 12 to 13 days before destroying them. This means it might now be technically possible to grow human embryos for a day or two past the 14-day limit adopted by many countries.
At a press conference in London, Magdalena Zernicka-Goetz at the…




